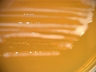

Accessioned in 1991.
=ATCC 11981 =CCM 1836 =NCFB 244 =NCIMB 6557 =NCTC 6557 =VKM B-577.
Lactobacillus rhamnosus.
Lactobacillus casei subsp. rhamnosus.
Medium: 1; Temperature: 30°C; Rehydration fluid: 663.
open link in new window

open link in new window
 Instructions for an order
Instructions for an order